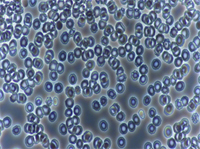

- All categories
- Dentist
- Optician
- Ophthalmologist
- Plastic Surgeon
- Psychologist
- Allergist/Immunologist
- Cardiologist
- Colon and rectal specialist
- Dermatologist
- GP (General Practitioner)
- Hematologist
- Neurologist
- Gynecologist
- Pediatrician
- Rheumatologist
- Sports Doctor
- Urologist
- Phlebologist
- Alternative medicine
- Rental
- More


Pittsburgh Alternative Health
Contacts
Book nowOpening hours
-
Sunday
Day off
-
Monday
8:00 AM - 8:00 PM
-
Tuesday
10:00 AM - 8:30 PM
-
Wednesday
8:00 AM - 5:30 PM
-
Thursday
8:30 AM - 7:00 PM
-
Friday
10:00 AM - 4:00 PM
-
Saturday
Day off
About the company
Pittsburgh Alternative Health strives to serve with Christian principles and integrity to deliver naturopathic care with uncompromising compassion...to educate with pure motives through example and discussion, a lifestyle of health...to seek and discover understanding of optimal methods of disease detection and supportive approaches to restore health.Our team

Doc Misak

Colon Hydrotherapy

Far Infrared Sauna

Ionic Foot Bath

Hyperbaric Therapy

BioMat Relaxation
Top services

Evening Initial In-Office 60 Minute Consultation (Children) plus EAV
120 min
Comprehensive 1 hour Initial Consultation includes 18 Parameter Urine and Saliva Screening Tests Plus 1 hour EAV

Evening Initial In-Office 60 Minute Consultation (Children) plus LBM
120 min
Comprehensive 1 hour Initial Consultation includes 18 Parameter Urine and Saliva Screening Tests Plus 1 hour Live Blood Microscopy (LBM)

Evening Initial In-Office 90 Minute Consultation (Adult) plus LBM
150 min
Comprehensive 1.5 hour Initial Consultation includes 18 Parameter Urine and Saliva Screening Tests Plus 1 hour Live Blood Microscopy (LBM)

Evening Initial In-Office 90 Minute Consultation (Adult) plus EAV
150 min
Comprehensive 1.5 hour Initial Consultation includes 18 Parameter Urine and Saliva Screening Tests Plus 1-hour EAV

(New) Initial In-Office 90 Minute Consultation (Adult) plus EAV
150 min
Comprehensive 1.5 hour Initial Consultation includes 18 Parameter Urine and Saliva Screening Tests Plus 1-hour EAV

Initial In-Office 90 Minute Consultation (Adult) plus EAV
150 min
Comprehensive 1.5 hour Initial Consultation includes 18 Parameter Urine and Saliva Screening Tests Plus 1-hour EAV

Initial In-Office 90 Minute Consultation (Adult) plus LBM
150 min
Comprehensive 1.5 hour Initial Consultation includes 18 Parameter Urine and Saliva Screening Tests Plus 1 hour Live Blood Microscopy (LBM)

Initial In-Office 90 Minute Consultation (Adult) plus LBM and EAV
210 min
Comprehensive 1.5 hour Initial Consultation includes 18 Parameter Urine and Saliva Screening Tests Plus 1 hour EAV and 1 hour Live Blood Microscopy.

EAV Balancing to Environmental Reactant
60 min
EAV Balancing to Environmental Reactant

Initial In-Office 60 Minute Consultation (Children) plus EAV
120 min
Children (Under Age 18) 1 Hour Initial Consultation includes 18 Parameter Urine and Saliva Screening Tests Plus 1 hour EAV.

Follow-Up & EAV Balancing to Environmental Reactant - Existing Patients only
60 min
Follow-Up & EAV Balancing to Environmental Reactant

Initial In-Office 60 Minute Consultation (Children) plus LBM and EAV
180 min
Children (Under Age 18) 1 Hour Initial Consultation includes 18 Parameter Urine and Saliva Screening Tests, Plus 1 hour Live Blood Microscopy (LBM), Plus 1 hour EAV.
Follow-Up & Live Blood Microscopy (LBM) Follow-Up
60 min
Follow-Up & Live Blood Microscopy live and dry evaluation-live only write-up

Follow-Up & Live Blood Microscopy (LBM) Screening
45 min
Follow-Up & Live Blood Microscopy Live evaluation only

Initial In-Office 60 Minute Consultation (Children) plus LBM
120 min
Children (Under Age 18) 1 Hour Initial Consultation includes 18 Parameter Urine and Saliva Screening Tests, Plus 1 hour Live Blood Microscopy (LBM)

(New) Initial In-Office 60 Minute Consultation (Children) plus LBM and EAV
180 min
Children (Under Age 18) 1 Hour Initial Consultation includes 18 Parameter Urine and Saliva Screening Tests, Plus 1 hour Live Blood Microscopy (LBM), Plus 1 hour EAV.

Follow-Up In-Office Consultation Plus EAV
90 min
Follow-Up and EAV Food/Chemical Sensitivity Screening includes updated testing list to include glyphosate and other common environmental concerns.

Follow-Up In-Office Consultation Plus LBM
90 min
Follow-Up & Live Blood Microscopy live and dry evaluation w/write up

Initial Colon Hydrotherapy Consultation
30 min

Initial Colon Hydrotherapy Session
90 min

Colon Hydrotherapy Session - after initial
60 min

BioMat Relaxation Therapy (45 Minute)
60 min

Far Infrared Sauna Session (30 minute)
30 min

Far Infrared Sauna Session (45 minute)
45 min

Ionic Foot Bath (45 Minutes)
45 min

Ionic Foot Bath (30 minute)
30 min

Initial mHBT (Mild Hyperbaric Therapy) Consultation
30 min

Break
30 min

M/A - Initial Consultation
60 min

M/A - Follow-Up Consultation
30 min

M/A - Phone Consultation
30 min

BioMat Relaxation Therapy (30 Minute)
45 min

RIFE
60 min

Ionic Foot Bath (60 Minutes)
60 min

Initial mHBT (Mild Hyperbaric Therapy) Session
90 min

mHBT Session (After Initial)
75 min

Follow-Up Consultation (30 min)
60 min

Follow-Up In-Office Consultation (30 minutes)
30 min
A Follow-Up consists of the 18 Parameter Urine/Saliva Screening and review of your Health State with Dr. Misak. This appointment usually runs 20-30 minutes.
Reviews
0 reviews





























